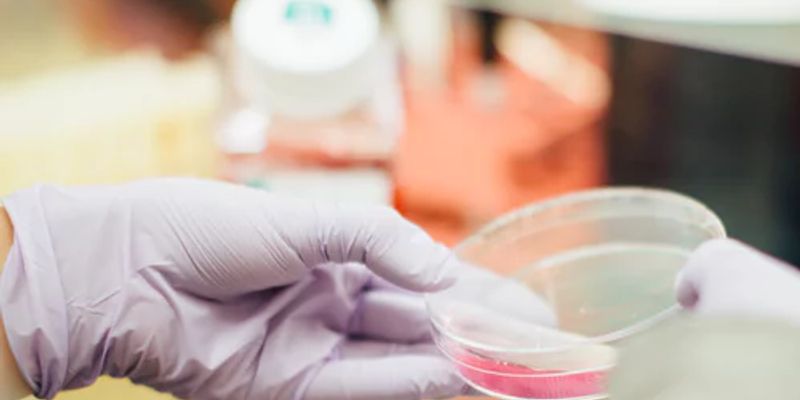

Tumor Angiogenesis
Tumor Angiogenesis: has been thought to be a valid treatment of many solid tumors and in particular their metastases. Tumor angiogenesis is initiated by the tumor itself. As soon as the malignancy grows to a certain size it becomes hypoxic and starts to secrete angiogenic growth molecules. Attempting to control angiogenesis is proving to be a promising tactic in limiting cancer progression.
What's Popular in Tumor Angiogenesis
-
FEB 29, 2024ImmunologyMyeloid cells are a population of cells classified to denote a specific lineage. “Myeloid” specifically refe ...Written By: Brian G. MorrealeOCT 18, 2022ImmunologyIntroduction The immune system plays a dual role in inflammation and cancer development. Immune system effector cells ra ...Sponsored By: Sino BiologicalFEB 14, 2022CancerValentine’s Day and chocolate go together like milk and cookies and peanut butter and jelly. CandyStore.com ...Written By: Katie KokolusJAN 07, 2022CancerThe blood-brain barrier (BBB) describes the complex vasculature network that delivers oxygen and nutrients to the brain. ...Written By: Katie KokolusDEC 19, 2021CancerTumors require blood vessels to obtain nutrients and growth factors needed for their expansion. Many tumors effici ...Written By: Katie Kokolus
FEB 29, 2024
Immunology
Myeloid cells are a population of cells classified to denote a specific lineage. “Myeloid” specifically refe
...
Written By:
Brian G. Morreale
OCT 18, 2022
Immunology
Introduction The immune system plays a dual role in inflammation and cancer development. Immune system effector cells ra
...
Sponsored By:
Sino Biological
FEB 14, 2022
Cancer
Valentine’s Day and chocolate go together like milk and cookies and peanut butter and jelly. CandyStore.com
...
Written By:
Katie Kokolus
JAN 07, 2022
Cancer
The blood-brain barrier (BBB) describes the complex vasculature network that delivers oxygen and nutrients to the brain.
...
Written By:
Katie Kokolus
DEC 19, 2021
Cancer
Tumors require blood vessels to obtain nutrients and growth factors needed for their expansion. Many tumors effici
...
Written By:
Katie Kokolus
OCT 28, 2021
Cancer
A family of proteins, known as transcription factors, regulate the biological process of converting DNA into RNA. T
...
Written By:
Katie Kokolus
OCT 25, 2021
Cancer
Pomegranate (Punica granatum L) is an ancient fruit grown primarily in western Asia and Mediterranean regions.
...
Written By:
Katie Kokolus
OCT 12, 2021
Immunology
What if a drug—specifically developed to treat one disease—had the potential to address other non-related co
...
Written By:
Tara Fernandes
SEP 20, 2021
Cancer
For the past several decades, cancer antigen 125 (CA 125), a protein located on the surface of ovarian cancer cells, has
...
Written By:
Katie Kokolus
-
OCT 19, 2022 | 10:00 AMDate: October 19, 2022 Time: 10:00am (PDT), 1:00pm (EDT), 7:00pm (CEST) In this webinar, we will introduce the generation and applications of Biocytogen’s severely immunodeficient (B-N...JUN 28, 2022 | 9:00 PMDate: June 29, 2022 Time: 12:00pm (PST), 2:00pm (EST), 8:00pm (CEST) The burden of antimicrobial resistance (AMR) has been acknowledged worldwide by leading health institutes. Besides the ne...OCT 08, 2020 | 10:00 AMDATE: October 8, 2020 TIME: 1:00pm PDT Microsatellite instability (MSI) has evolved as a marker of potential hereditary cancer risk and is now a tissue agnostic immune biomarker with a broad...Extracellular vesicles (EVs) are nanosized vesicles containing active proteins, lipids, and different types of genetic material such as non coding RNA species, related to the characteristics...
Immune checkpoint blockade has revolutionized the treatment for patients with cancer. Great efforts remain to better understand resistant mechanisms to treatment as well as means to improve...
OCT 19, 2022 | 10:00 AM
Date: October 19, 2022 Time: 10:00am (PDT), 1:00pm (EDT), 7:00pm (CEST) In this webinar, we will introduce the generation and applications of Biocytogen’s severely immunodeficient (B-N...
JUN 28, 2022 | 9:00 PM
Date: June 29, 2022 Time: 12:00pm (PST), 2:00pm (EST), 8:00pm (CEST) The burden of antimicrobial resistance (AMR) has been acknowledged worldwide by leading health institutes. Besides the ne...
OCT 08, 2020 | 10:00 AM
DATE: October 8, 2020 TIME: 1:00pm PDT Microsatellite instability (MSI) has evolved as a marker of potential hereditary cancer risk and is now a tissue agnostic immune biomarker with a broad...
Extracellular vesicles (EVs) are nanosized vesicles containing active proteins, lipids, and different types of genetic material such as non coding RNA species, related to the characteristics...
Immune checkpoint blockade has revolutionized the treatment for patients with cancer. Great efforts remain to better understand resistant mechanisms to treatment as well as means to improve...
NOV 15, 2018 | 7:00 AM
The use of human pluripotent stem cells (hPSCs) for in vitro disease-modeling is limited by the lack of robust and efficient protocols for the differentiation of relevant adult cell types. Pr...
Transcriptional profiling of the tumor microenvironment can lead to insights about the interaction between the tumor and immune system. This facilitates investigation of immune evasion mechan...
Speaker:
Sarah Warren, PhD
, Patrick Danaher, PhD
Presented at: Clinical Diagnostics & Research Virtual Event Series 2017
Sponsored By: NanoString Technologies
Sponsored By: NanoString Technologies
DATE: June 30, 2016
TIME: 8:00am Pacific time, 11:00am Eastern time
Focusing solely on malignant cancer cells and the genes that they express is modestly just a glimpse of the...
DATE: October 28th, 2015TIME: 11am Pacific time, 2pm Eastern timeNew discoveries uncover that exposure to current environmental, dietary, behavioral, and medical conditions can significantly...